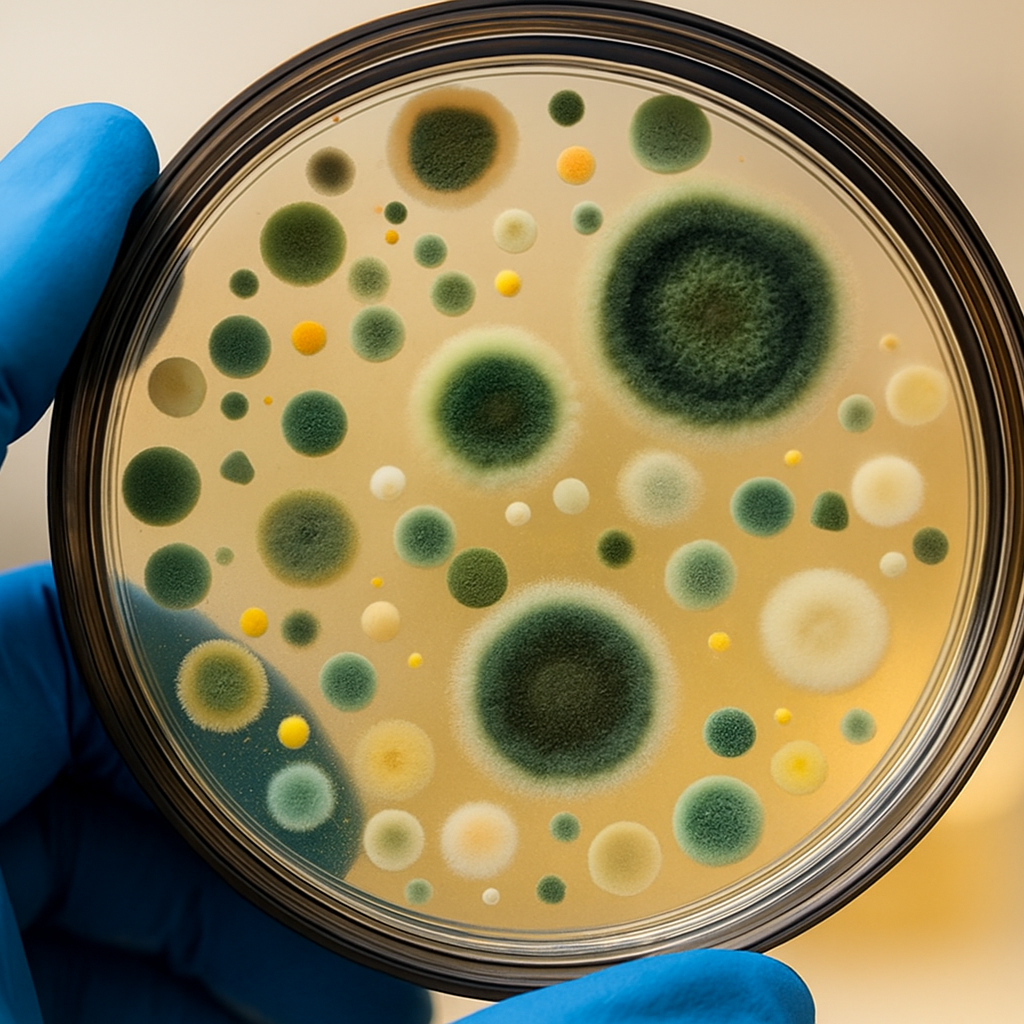

Our professional mold inspection and testing services are designed to uncover hidden mold problems and identify the source of contamination before they spread. Using advanced technology and certified inspection methods, we provide accurate results and peace of mind for homeowners and businesses throughout Pickering.
Our process includes:
Moisture Mapping: We identify hidden moisture within walls, ceilings, and floors—the root cause of most mold growth.
Infrared Scanning: Using thermal imaging cameras, we detect temperature changes that reveal moisture and potential mold behind surfaces.
Air Sampling: Our air quality tests measure airborne mold spores to determine contamination levels and health risks.
Surface Sampling: We collect and analyze surface samples to identify mold species and confirm contamination sources.
Detailed Reporting: Every inspection includes a comprehensive, easy-to-read report outlining findings, lab results, and professional remediation recommendations.
You get precise results, expert analysis, and honest guidance from certified mold inspectors committed to protecting your property and health.